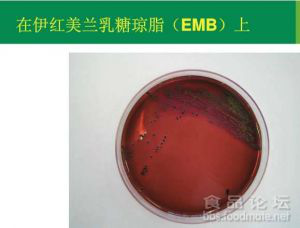

400-081-4789
400-081-4789Information Center
首頁 / 信息中心 / 微生物知識
時間:2020-11-19 來源:admin 點擊:1713次
?指一群在36℃條件下培養48h能發酵乳糖、產酸產氣的需氧和兼性厭氧革蘭氏陰性無芽胞桿菌。
?該菌群主要來源于人畜糞便, 作為糞便污染指標評價食品的衛生狀況, 推斷食品中腸道致病菌污染的可能。
?大腸菌群不是細菌學上分類命名,而是一組與糞便污染有關的細菌。這群細菌包括:大腸埃希氏菌、檸檬酸桿菌、產氣克雷伯氏菌和陰溝腸桿菌。
?生化特征及血清學反應并非完全一致。
2.分布:
–廣泛分布于自然環境。
–來源于人和溫血動物的糞便。
3.衛生學意義
–大腸菌群作為糞便污染的指標菌評價樣品中是否受到糞便的污染。
–大腸菌群計數的高低,直接反映了樣品受糞便污染的程度。
–表示對人體健康是否具有潛在的危險性。
大腸菌群是理想的糞便污染的指標菌
–是人類和溫血動物腸道菌群,在數量上占優勢。
–隨糞便排出體外后,在外界環境影響下,其存活時間應與腸道致病菌大致相似或稍長。
–檢驗方法簡便,易于檢出與計數。
–對消毒劑的抵抗力應不低于腸道致病菌。
4.主要修改內容
將原標準拆分為大腸菌群、糞大腸菌群和大腸桿菌計數三個獨立的標準方法,標準名稱變化。
大腸菌群的MPN法中乳糖膽鹽等培養基改為月桂基硫酸鹽胰蛋白眎(LST)肉湯為主的培養基;
增加了對樣品勻液的pH范圍要求;
增加了大腸菌群的平板計數法;
MPN法的結果報告由原每100g(mL)大腸菌群的MPN值,修改為每1 g(mL)大腸菌群的MPN值
5.大腸菌群在不同培養基上的形態

本文摘自《食品伙伴網》